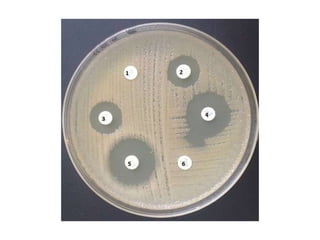
Tema11.1 eso (microorganismos)

Este documento resume los cinco reinos biológicos, incluyendo protistas, moneras, virus, y hongos. Detalla las características de los protozoos y algas, incluyendo que los protozoos son heterótrofos y unicelulares mientras que las algas son autótrofas y pueden ser unicelulares o pluricelulares. También explica los mecanismos de transmisión de enfermedades infecciosas como la transmisión directa e indirecta, y los métodos de defensa del cuerpo como las barreras físic